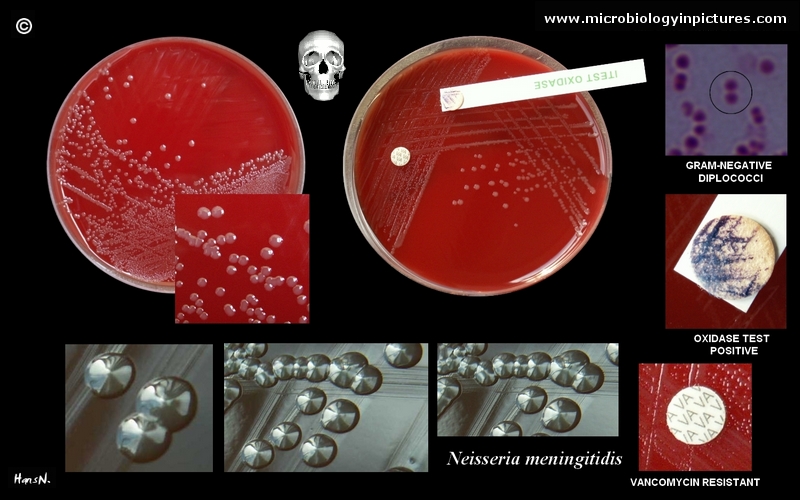

原创:仰光省卫生局发布警惕仰光全省脑膜炎病毒蔓延
编辑:缅华网
文章类型:缅甸新闻
发布于2016-03-22 11:34:12
共1933人阅读
文章导读
原创:仰光省卫生局发布警惕仰光全省脑膜炎病毒蔓延
仰光省卫生局发布警惕在仰光全省蔓延脑膜炎病毒警告书。
3月14日及18日,仰光省南达贡市镇21区发生两名儿童患脑膜炎病毒死亡,并对怀疑患脑膜炎病毒的21名儿童留院观察。
仰光省卫生局局长温伦医师表示,“巳向仰光全省发出通知,仰光省已发现脑膜炎病毒,要注意病毒的蔓延,并加以预防,特别要注意人群集中的地方,病毒是通过呼吸道传染的”。年老的、怀孕的、幼小儿童等在灰尘多的地方最易受感染,一定要保持充分的营养、保持身躯干净清洁。
根据2014年人口普查结果,仰光全省辖四个县46个市镇,1582944个户口,人口7360703名。
缅华网 华轩报导
0
0
评论列表 共有 0 条评论
最新导读

热门文章
















发表评论 取消回复